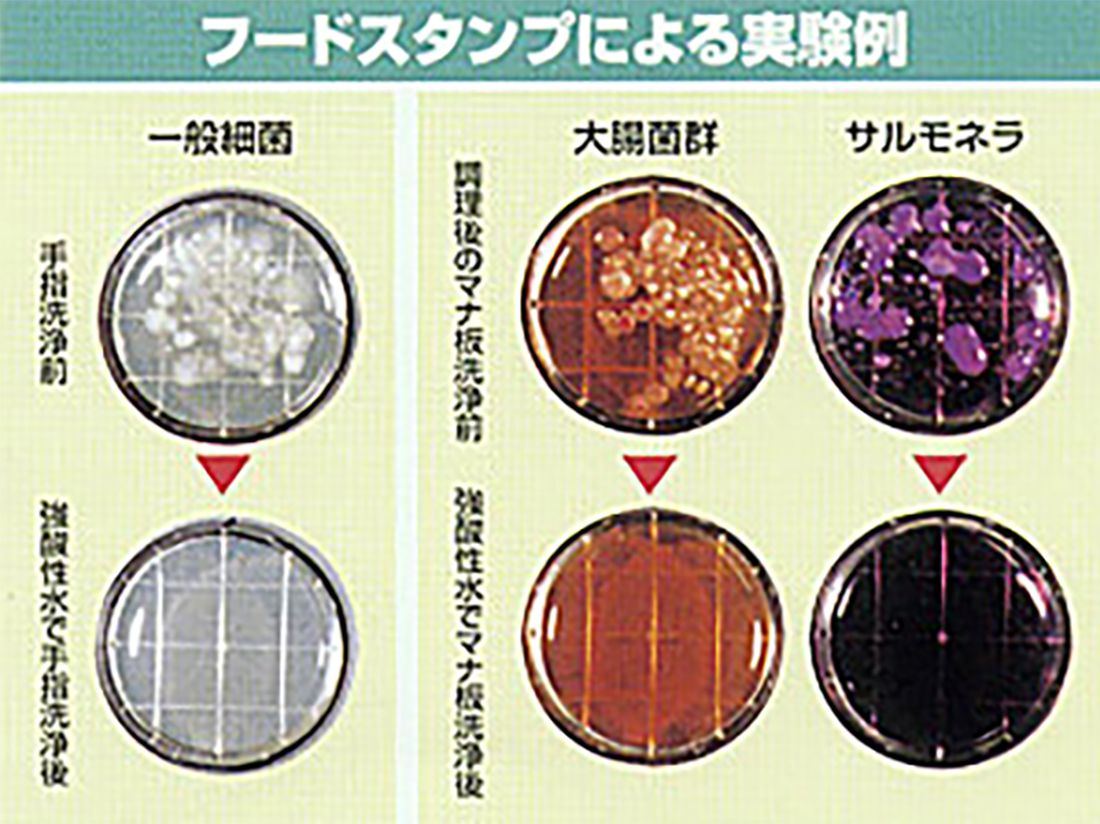
実験例

強酸性電解水とは

限りなく水に近い強酸性電解水
強酸性電解水は、微量な食塩を添加した水道水を、電気分解することにより、陽極側からは強い酸性の水(強酸性電解水)、陰極側からは強いアルカリ性の水(強アルカリ水)が生成されます。
| 水素イオン濃度 | ㏗2.3~2.7 |
|---|---|
| 酸化還元電位 | +700㎷~+1000㎷ |
電解層内の2つの電極(陽極、陰極)間に隔膜を置き、水道水に電解補助剤(塩化ナトリウム等)を添加。所定の条件下で電気分解することにより、陽極側に強酸性電解水が、陰極側に強アルカリ性電解水が生成されます。(これを有隔膜電解といいます)陽極側にできる強酸性電解水には塩素ガスが溶解しており、この塩素ガスから生成される次亜塩素酸(HCIO)の働きにより微生物を殺菌、強力な洗浄消毒作用を発揮します。
一方、陰極側にできる強アルカリ性電解水は蛋白質系・脂質系の汚れに洗浄効果のある水酸化ナトリウム(NaOH)が生成されます。